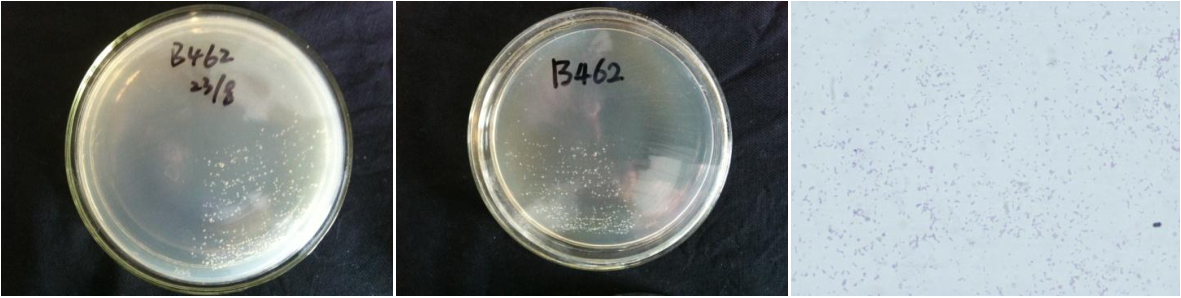

Loading...
| StrainNO | B462 |
| Classification | Pseudomonas |
| 16s rDNA sequence | GGGAATCCCTCCCGTGGGTACCGTCGCCCCGAAGGTTAGACTAGCTACTTCTGGAGCAACCCACTCCCATGGTGTGACGGGCGGT GTGTACAAGGCCCGGGAACGTATTCACCGTGACATTCTGATTCACGATTACTAGCGATTCCGACTTCACGCaGtCGAGTTGCAGA CTGCGATCCGGACTACGATCGGTTTTATGGGATTAGCTCCACCTCGCGGCTTGGCAACCCTTTGTACCGACCATTGTAGCACGTG TGTAGCCCAGGCCGTAAGGGCCATGATGACTTGACGTCATCCCCACCTTCCTCCGGTTTGTCACCGGCAGTCTCCTTAGAGTGCC CACCATAACGTGCTGGTAACTAAGGACAAGGGTTGCGCTCGTTACGGGACTTAACCCAACATCTCACGACACGAGCTGACGACAG CCATGCAGCACCTGTGTCTGAGTTCCCGAAGGCACCCCGCCATCTCTGGCAGGTTCTCAGCATGTCAAGGCCTGGTAAGGTTCTT CGCGTTGCTTCGAATTAAACCACATGCTCCACCGCTTGTGCGGGCCCCCGTCAATTCATTTGAGTTTTAACCTTGCGGCCGTACT CCCCAGGCGGTCGACTTAATGCGTTAGCTGCGCCACTAAGATCTCAAGGATCCCAACGGCTAGTCGACATCGTTTACGGCGTGGA CTACCAGGGTATCTAATCCTGTTTGCTCCCCACGCTTTCGCACCTCAGTGTCAGTATTAGCCCAGGTGGTCGCCTTCGCCACTGG TGTTCCTTCCTATATCTACGCATTTCACCGCTACACAGGAAATTCCACCACCCTCTGCCATACTCTAGCTTGCCAGTTTTGGATG CAGTTCCCAGGTTGAGCCCGGGGCTTTCACATCCAACTTAACAAACCACCTACGCGCGCTTTACGCCCAGTAATTCCGATTAACG CTTGCACCCTTCGTATTACCGCGGCTGCTGGCACGAAGTTAGCCGGTGCTTATTCTGTCGGTAACGTCAAAACAGCAAGGTATTA ACTTACTGCCCTTCCTCCCAACTTAAAGTGCTTTACAATCCGAAGACCTTCTTCACACACGCGGCATGGCTGGATCAGGCTTTCG CCCATTGTCCAATATTCCCCACTGCTGCCTCCCGTAGGAGTCTGGACCGTGTCTCAGTTCCAGTGTGACTGATCATCCTCTCAGA CCAGTTACGGATCGTCGCCTTGGTGAGCCATTACCTCACCAACTAGCTAATCCGACCTAGGCTCATCTGATAGCGCAAGGCCCGA AGGTCCCCTGCTTTCTCCCGTAGGACGTATGCGGTATTAGCGTTCCTTTCGAAACGTTGTCCCCCACTATCAGGCAGATTCCTAG GCATTACTCACCCGTCCGCCGCTGAATCCGGGAGCAAGCTCCCTTCATCCGCTCGACTGCATGTGTAGCCCTCCCCCCC |
| Strain Morphology Photos | |
| Morphological Description | Colony round;small;clam white;edge neatly;bright;sticky;translucent;Bacteriophage Rod-shaped;no spore |